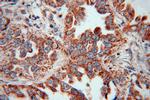
KRAS-2A Antibody in Immunohistochemistry (Paraffin) (IHC (P))

Search
Proteintech
KRAS-2A Polyclonal Antibody
{{$productOrderCtrl.translations['antibody.pdp.commerceCard.promotion.promotions']}}
{{$productOrderCtrl.translations['antibody.pdp.commerceCard.promotion.viewpromo']}}
{{$productOrderCtrl.translations['antibody.pdp.commerceCard.promotion.promocode']}}: {{promo.promoCode}} {{promo.promoTitle}} {{promo.promoDescription}}. {{$productOrderCtrl.translations['antibody.pdp.commerceCard.promotion.learnmore']}}
产品信息
16156-1-AP
种属反应
宿主/亚型
分类
类型
抗原
偶联物
形式
浓度
规格
纯化类型
保存液
内含物
保存条件
运输条件
产品详细信息
This antibody is specific for KRAS-2A, which also named as KRAS-4A.
靶标信息
This gene belongs to the Ras oncogene family, whose members are related to the transforming genes of mammalian sarcoma retroviruses. The products encoded by these genes function in signal transduction pathways. These proteins can bind GTP and GDP, and they have intrinsic GTPase activity. This protein undergoes a continuous cycle of de- and re-palmitoylation, which regulates its rapid exchange between the plasma membrane and the Golgi apparatus. Mutations in this gene cause Costello syndrome, a disease characterized by increased growth at the prenatal stage, growth deficiency at the postnatal stage, predisposition to tumor formation, mental retardation, skin and musculoskeletal abnormalities, distinctive facial appearance and cardiovascular abnormalities. Defects in this gene are implicated in a variety of cancers, including bladder cancer, follicular thyroid cancer, and oral squamous cell carcinoma. Multiple transcript variants, which encode different isoforms, have been identified for this gene.
仅用于科研。不用于诊断过程。未经明确授权不得转售。
生物信息学
蛋白别名: c-K-ras; c-Ki-ras; c-Kirsten-ras protein; c-ras-Ki-2 protein; cellular c-Ki-ras2 proto-oncogene; cellular transforming proto-oncogene; GTPase KRas; K RAS; K-Ras 2; K-ras p21 protein; Ki-Ras; Kirsten rat sarcoma viral oncogene homolog; Kirsten rat sarcoma viral proto-oncogene; KRAS-ENOPH fusion; Kras-Enoph1 fusion protein; oncogene KRAS2; PR310 c-K-ras oncogene; PR371 c-K-ras oncogene; proto-oncogene GTPase; small GTP binding protein; transforming protein p21; unnamed protein product; v-Ki-ras2 Kirsten rat sarcoma 2 viral oncogene homolog
基因别名: 'C-K-RAS; C-K-RAS; c-Ki-ras; c-Ki-ras2; CFC2; K-Ras; K-Ras 2; K-RAS2A; K-RAS2B; K-RAS4A; K-RAS4B; KI-RAS; KRAS; KRAS1; KRAS2; NS; NS3; OES; RALD; RASK2
UniProt ID: (Human) P01116
Entrez Gene ID: (Human) 3845